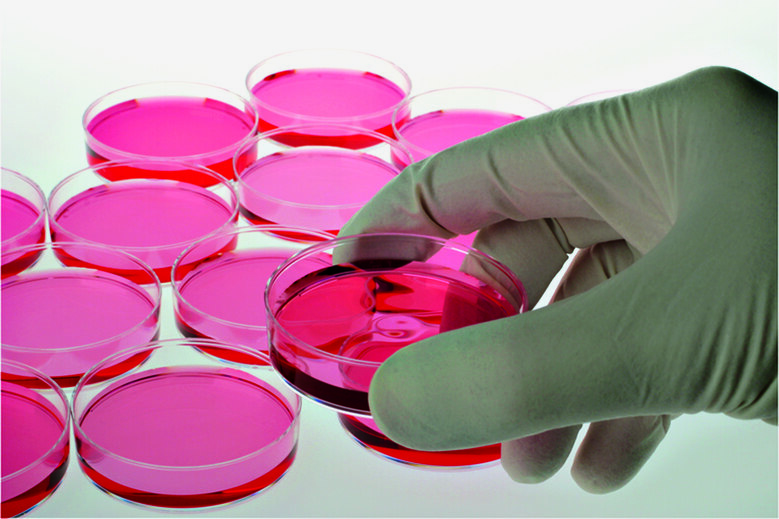
Petrischalen

Max-Planck-Gesellschaft
Die Max-Planck-Gesellschaft (MPG) betreibt Grundlagenforschung in den Natur, Lebens- und Geisteswissenschaften im Dienste der Allgemeinheit. Mit der großen Zahl von Nobelpreisträgern in und aus ihren Reihen sowie ihren Instituten, die zu den weltweit besten und angesehensten Forschungsinstitutionen zählen, ist sie ein internationales Aushängeschild für die deutsche Wissenschaft. www.mpg.de
Unter dem Dach der Max-Planck-Gesellschaft haben sich im Freistaat Sachsen seit 1990 sechs Institute angesiedelt, die ein starkes Gerüst für langfristige und hervorragende Grundlagenforschung in den Lebens- und Naturwissenschaften bilden. Aus der Initiative der Max-Planck-Gesellschaft und der Technischen Universität Dresden ging inzwischen eine weitere Einrichtung hervor – das Zentrum für Systembiologie Dresden (CSBD). Letzteres steht dabei exemplarisch für die enge Kooperation von Max-Planck-Instituten und Hochschulen im Freistaat Sachsen. Als weitere Beispiele der erfolgreich gelebten Zusammenarbeit seien die Wissenschaftsnetzwerke an den Universitätsstandorten Dresden und Leipzig sowie das gemeinsame Engagement bei der Förderung des wissenschaftlichen Nachwuchses wie etwa in Internationalen Max-Planck-Research-Schools, Sonderforschungs-bereichen und Graduiertenkollegs genannt.
Im Jahr 2009 übernahm der Freistaat Sachsen die Länder-Patenschaft für eines der fünf Auslandsinstitute der Max-Planck-Gesellschaft, der 1913 gegründeten Bibliotheca Hertziana, Max-Planck-Institut für Kunstgeschichte in Rom. Dieses Institut ist eines der ältesten Max-Planck-Institute und beschäftigt sich mit der Erforschung der italienischen Kunst der Nachantike in Rom.
Max-Planck-Institut für Kunstgeschichte
Das Max-Planck-Institut für evolutionäre Anthropologie in Leipzig gehört in den Kreis der Institutionen, die einen Nobelpreisträger in ihren Reihen haben. Direktor am Institut Prof. Dr. Svante Pääbo erhielt 2022 den Medizinnobelpreis für die Begründung des neuen Forschungsgebietes Paläogenetik. Mit der Berufung von Svante Pääbo in den Gründungsstab des Instituts 1997 wurde eine Forscherpersönlichkeit von hohem wissenschaftlichen Rang auf dem Gebiet der genetischen und evolutionsbiologischen Grundlagenforschung mit großem internationalen Ansehen nach Leipzig geholt. Seine hohe fachliche Reputation sowie sein großes Engagement bei der Leitung des MPI führten dazu, dass das Institut heute einen exzellenten Namen in der internationalen Fachwelt hat und mit der Verleihung des Nobelpreises für Medizin die bedeutendste wissenschaftliche Anerkennung erhielt.
Pressemitteilung des MPI eva
Webseite: http://www.mpipks-dresden.mpg.de/de/
Webseite: http://www.cpfs.mpg.de/de
Webseite: https://www.mpi-cbg.de/de/home/
Webseite: http://www.eva.mpg.de/german/index.html
Webseite: https://www.mis.mpg.de
Webseite: http://www.cbs.mpg.de/de